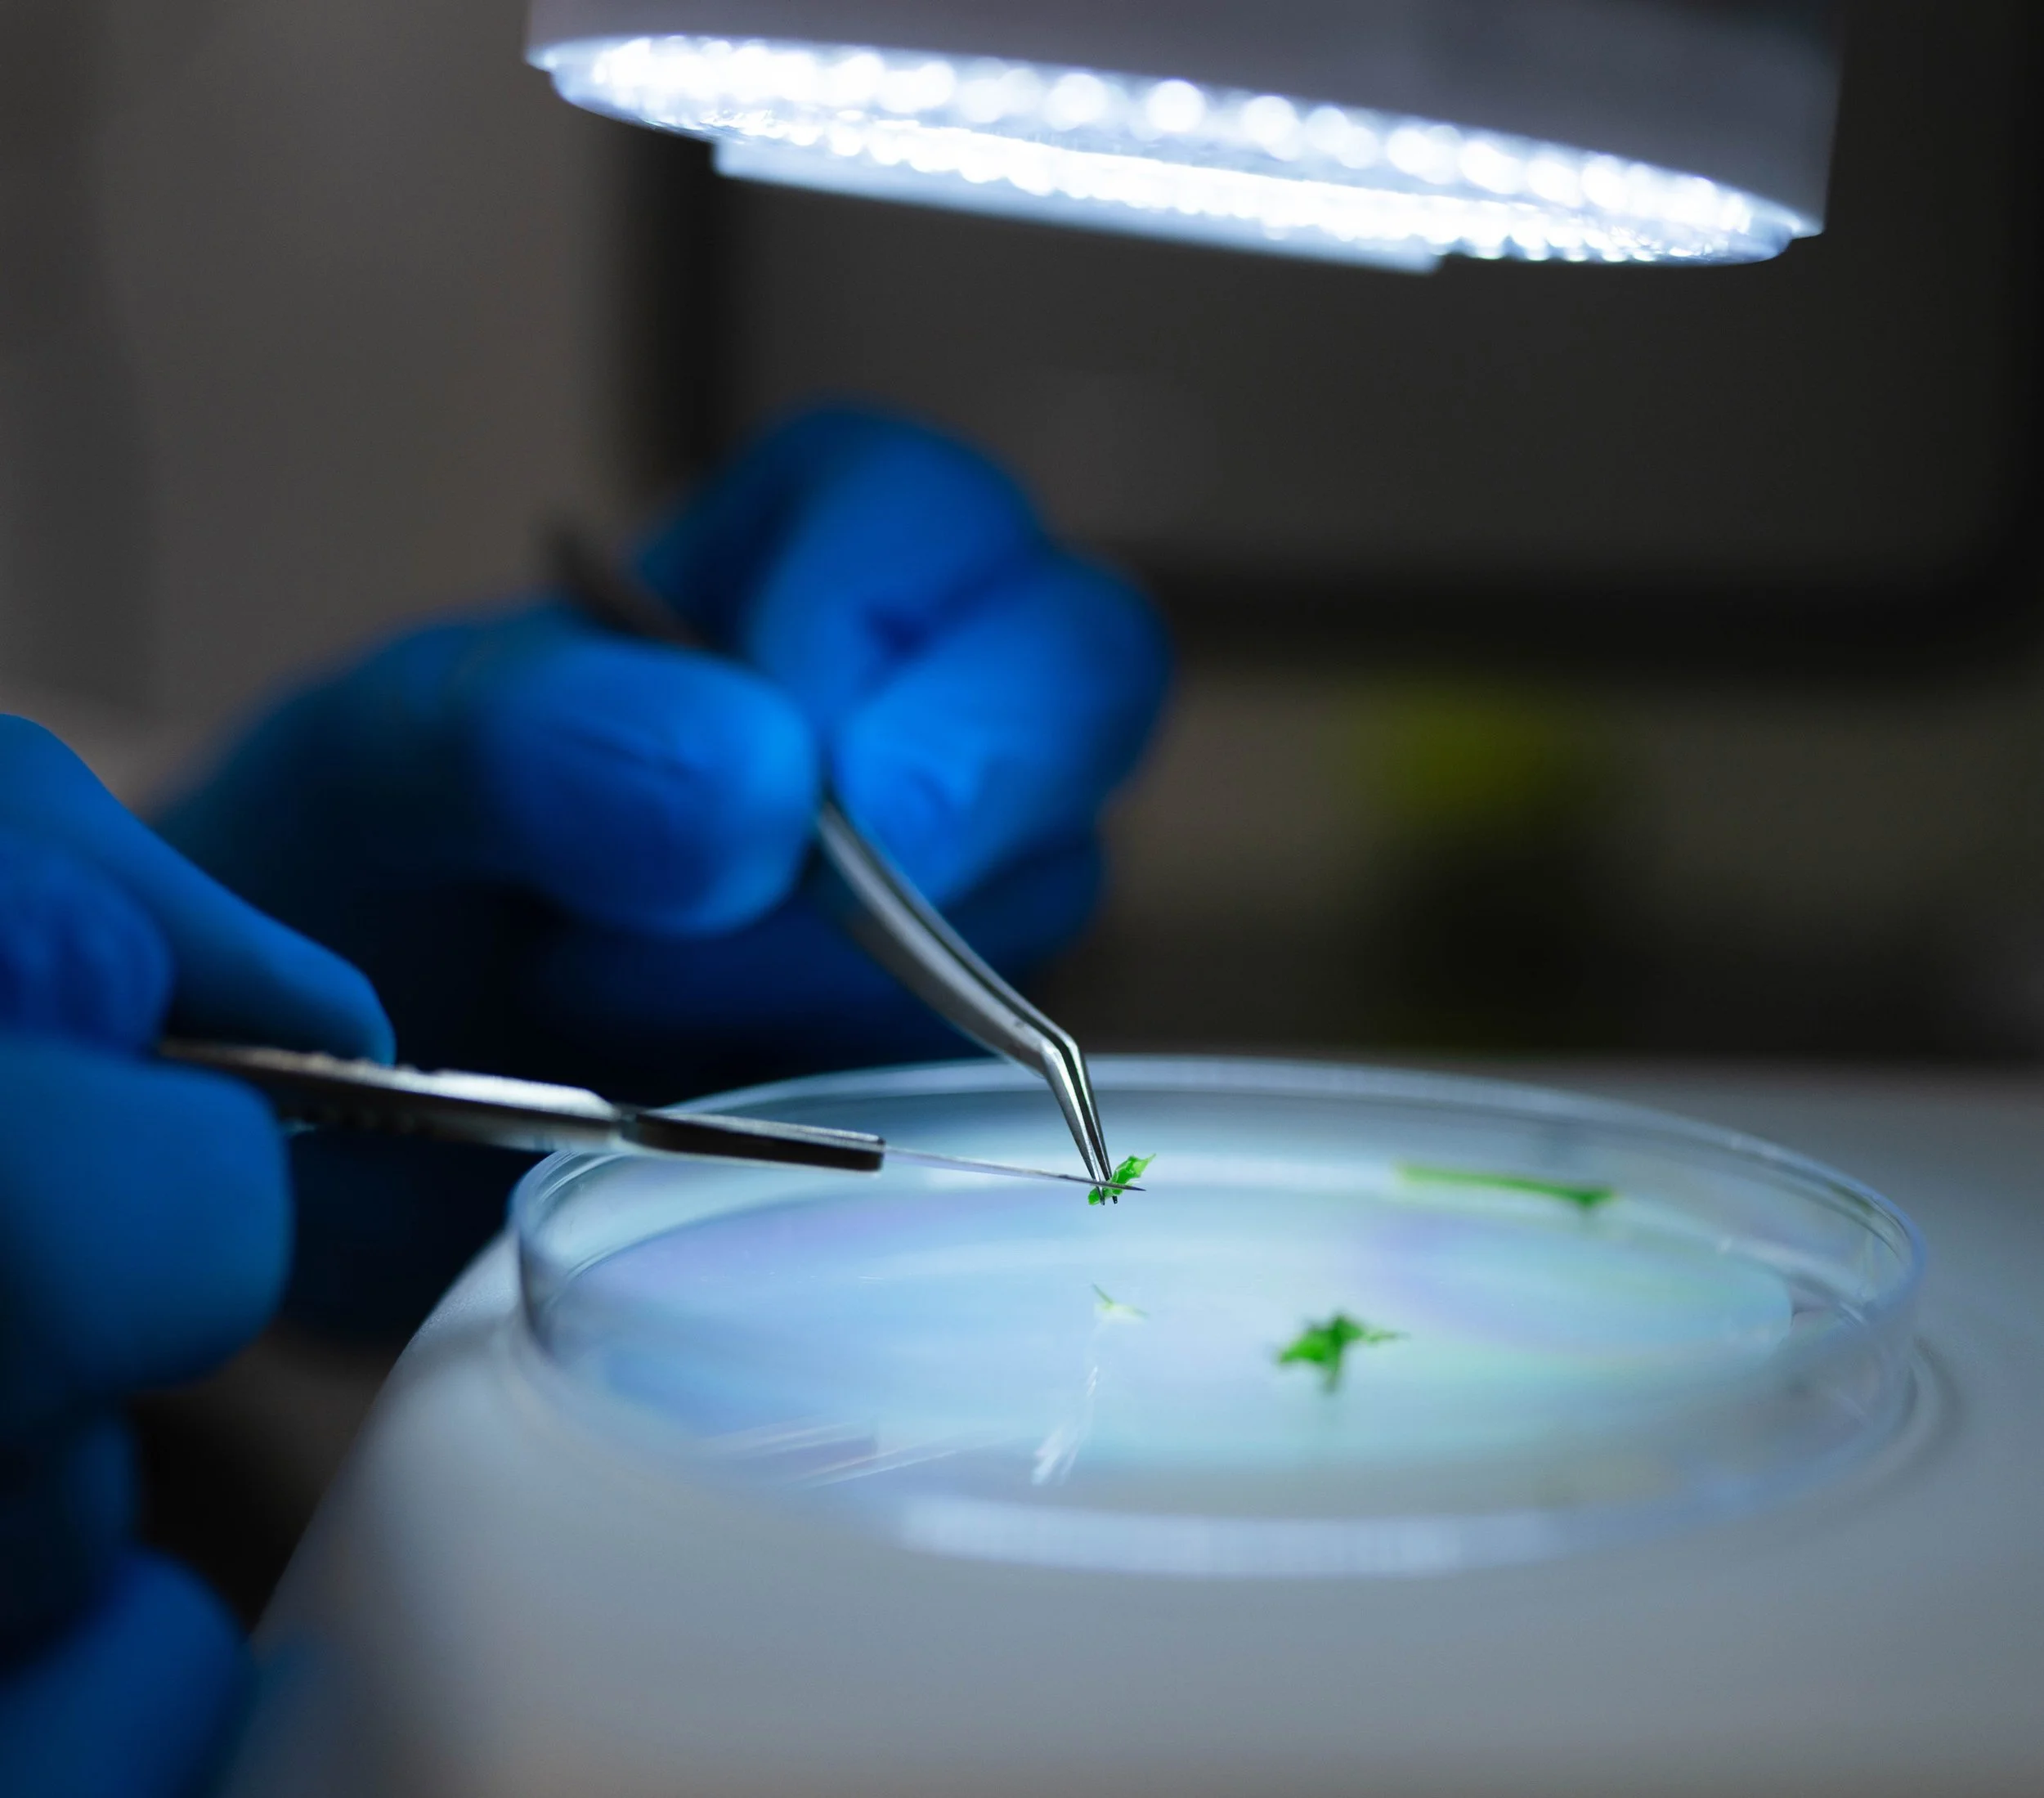

Meet GCI:
Where Cannabis Culture, Science, and Business Converge
Rich in 100% privately-owned hard assets, GCI is expanding rapidly in California and poised for explosive growth via national and global partnerships.

View GCI Overview
GCI. The First Platform that Consistently, Predictably Produces Massively-Popular Cannabis Strains.
Genetics drives cannabis.
Recognizable cannabis varieties help consumers know what to purchase at retail and they help growers know what to plant.
The challenge is knowing in advance which varieties will catch on with consumers. It’s a dilemma that plagues cannabis breeders, clone nurseries, cannabis seed companies, cultivators, finished goods manufacturers and cannabis investors.
Creating a model that consistently, predictably produces winning genetics has long been the holy grail of the cannabis industry.
Introducing GCI–Green Capital Investments. The first ever platform that produces trend-leading cannabis varieties again and again and again.
Varieties like Sundae Driver, Fatso, Gusherz, Lava Cake, Wedding Pie, Crostata, Grapes & Cream, Kush Crasher and Carbon Fiber to name a few. All household names and massive, million-pound-selling cannabis strains over the past five years. And all a product of the GCI cannabis genetics-development platform and process.
Our platform utilizes a pioneering combination of internal and third party Breeding Programs, a data-intensive genetic characterization process, advanced tissue-culture technology and unmatched production resources to rapidly scale winning varieties. As a whole, the platform empowers GCI to drive consumer tastes in cannabis genetics year after year.
Read on to learn more about how you can become involved with this powerful platform that is expanding across the US and internationally, changing the future of cannabis forever.

How We Got Here
It wasn’t always easy. Or pretty. We didn’t always make the right choices.
But we’re a small team of extremely dedicated and resourceful individuals who fundamentally believe in the healing powers of clean cannabis.
That belief led us to stand strong when others bolted. To continue investing when others cut their losses. To remain positive and keep building when others lost hope.

Where We’re Heading
The result of this dogged determination and unwavering belief in the power of clean cannabis is today’s GCI: A supply chain powerhouse in the California cannabis industry that is rapidly becoming a player on the national and global stage.
GCI has developed the first cannabis genetics platform, proven to produce multiple winning cannabis varieties each and every year. The platform consists of an unmatched Breeding Program, California’s largest indoor clone nursery, most advanced tissue culture program, multiple cultivation facilities for characterization, a statewide bulk flower distribution network and now expansion into multiple states and countries.
A Revolutionary Approach to Clean Plant Technology
Phinest Tissue Culture has a single powerful mission: to extend elite, healthy genetics to cannabis cultivators worldwide. We are elevating the cannabis industry to the standards of modern agriculture by making clean stock widely available.

California’s Largest Indoor Cannabis Nursery
Capable of producing more than 4M tissue culture clones per year, GCI's Phinest Cannabis Nursery in Sacramento is California’s largest and most advanced.

Cannabis Cultivation:
A Powerful Key to our Success
For GCI, cultivation is more than a business. It’s key to the success of all our businesses.
We employ cultivation primarily as a means to characterize the dozens of new cannabis genetics we produce each year from our internal breeding activities, and those received from the stable of world-class breeders enrolled in our third-party Breeding Program.

Cultivating Relationships With The World's Best Cannabis Breeders
Breeding fine cannabis is an art form. Our Breeder Program attracts the very best by providing a structured, professional environment where breeders can have their work objectively evaluated and thoroughly characterized.

Phinest Distribution:
A Statewide Network Providing Exceptional Service
Our distribution evolved organically to address the growing industry need for consistent supply chain and delivery services with streamlined access to the highest quality California clean cannabis. Our foundation is built upon decades of experience amongst our team who specialize in agriculture, horticulture, cultivation, transportation, and retail, as well as business development. We know every step from seed to sale, and support our customers every step of the way.
Meet Our Team
In Memoriam













